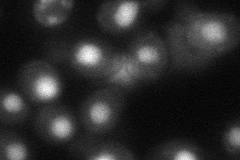
YPL212C

View description
tRNA:pseudouridine synthase, introduces pseudouridines at positions 26-28, 34-36, 65, and 67 of tRNA; nuclear protein that appears to be involved in tRNA export; also acts on U2 snRNA
Localization:
Intensity:
Fold change:
Significance:
-
C’ GFP library in SD

nucleus67.64 -
N' NOP1pr-GFP in SD

nucleus94.4269 -
N' TEF2pr-mCherry in SD

nucleus10.0265 -
N' NATIVEpr-GFP in SD

nucleus54.3427 -
N' TEF2pr-VC and Cyto-VN in SD
nucleus49.7636 -
C’ GFP library in SD+DTT

nucleus53.370.78No -
C’ GFP library in SD+H2O2

nucleus70.581.04No -
C’ GFP library in Starvation Media

nucleus35.330.52Yes -
C’ GFP library on the background of Pup2-DaMP

nucleus -
C’ GFP library on the background of CCT mutant

nucleus72.28941.06864No
